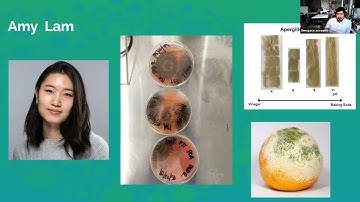
Sustainability Awareness Week 2021: Collaborations with Nature -- The FIT Genspace Scholars Program

⬇ DOWNLOAD NOW
Kalau muncul iklan pop-up, tutup lalu klik tombol kembali
Download lagu Genspace program: Hands-on training in a community setting to develop science identity secara gratis hanya untuk keperluan promosi. Dukung artis favorit kamu dengan membeli musik original di iTunes atau platform resmi lainnya.
 Get to know Genspace
Get to know Genspace
 Collaborations with Nature -- The FIT Genspace Scholars Program
Collaborations with Nature -- The FIT Genspace Scholars Program
Sustainability Awareness Week 2021: Collaborations with Nature -- The FIT Genspace Scholars Program
Sustainability Awareness Week 2021: Collaborations with Nature -- The FIT Genspace Scholars Program
 A Visit to Genspace
A Visit to Genspace
 Spaces & Places: Genspace - New York's Community Biolab
Spaces & Places: Genspace - New York's Community Biolab
 Watch this GenSpace - by Nature Video
Watch this GenSpace - by Nature Video
 Genspace: BioMaker Lab Tour - Empire State Maker Faire
Genspace: BioMaker Lab Tour - Empire State Maker Faire
 Inside Genspace: Exploring the theory of change behind the world's 1st community biology lab
Inside Genspace: Exploring the theory of change behind the world's 1st community biology lab